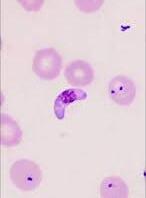

Universidad de Antioqua producirá Cloroquina

Invima da el aval

Kenvue se reinventa
Línea alternativa a Tylenol
Colombia pierde terreno
Competitividad en descenso



Kenvue se reinventa
Línea alternativa a Tylenol
Colombia pierde terreno
Competitividad en descenso

Daprodustat (Duvroq®) es un inhibidor de la prolil hidroxilasa (PHD), un factor inducible por hipoxia, desarrollado por GlaxoSmithKline para el tratamiento de la anemia en pacientes con enfermedad renal crónica (ERC). La inhibición de la PHD previene la degradación del factor inducible por hipoxia (HIF), lo que favorece la producción de eritropoyetina y la consiguiente eritropoyesis. GlaxoSmithKline (GSK) firmó un acuerdo con Kyowa Hakko Kirin para la comercialización de daprodustat en Japón para su uso en pacientes con anemia de ERC. En junio de 2020, daprodustat recibió su primera aprobación en Japón para el tratamiento de la anemia renal.


Nombres alternativos
Nombre IUPAC
Clase
Mecanismo de acción
Ruta de administración
Farmacodinámica
1278863; DUVROQa ; GSK-1278863; GSK-1278863A
N-[(1,3-Diciclohexilhexahidro-2,4,6-trioxopirimidin-5-il)carbonil]glicina
Antiisquémicos; antianémicos; pirimidinas; terapias para trastornos de la piel; moléculas pequeñas
Inhibidor de la prolil hidroxilasa
Oral
Aumento de los niveles de eritropoyetina, recuento de reticulocitos y niveles de hemoglobina en ratones. Reducción de los niveles medios de ferritina, saturación de transferrina y niveles de hepcidina, y aumento de la capacidad total de fijación del hierro en pacientes con anemia por enfermedad renal crónica.
Farmacocinética
Efectos adversos
Código ATC
Tmax 1–4 h, Unión a proteínas del plasma ≈ 99%, excretado principal en las heces, t½ ≈ 3 h
Hemorragia retiniana, hipersensibilidad (erupción cutánea, dermatitis, urticaria) e hipertensión arterial
B03XA07; B03 (preparados antianémicos); B03XA (Otras preparaciones antianémicas).
En adultos con enfermedad renal crónica (ERC) que no reciben diálisis, la dosis inicial recomendada de daprodustat en pacientes no tratados con un agente estimulante de la eritropoyesis (AEE) es de 2 mg (para niveles de Hb ≥9,0 g/dl) o 4 mg (para niveles de Hb <9,0 g/dl) administrados por vía oral una vez al día. En adultos que cambian de AEE, la dosis inicial recomendada de daprodustat es de 4 mg administrados por vía oral una vez al día.
En pacientes dependientes de diálisis, la dosis inicial recomendada de daprodustat es de 4 mg administrados por vía oral una vez al día, independientemente de si los pacientes reciben AEE o si cambian de AEE.
Posteriormente, la dosis de daprodustat puede ajustarse (máximo 24 mg una vez al día) según la gravedad de la anemia.
Fuente: https://link.springer.com/article/10.1007/s40265-020-01384-y








Alcon, líder mundial en cuidado ocular dedicado a ayudar a las personas a ver con claridad, anunció que la FDA ha aprobado
Tryptyr® ( solución oftálmica de acoltremon) al 0,003 %, anteriormente conocido como AR-15512, para el tratamiento de los signos y síntomas de la enfermedad del ojo seco (EOS). Acoltremon es un agonista del receptor TRPM8 (neuromodulador) pionero en su clase que estimula los nervios sensoriales de la córnea para aumentar rápidamente la producción natural de lágrimas.
La EOS es una afección compleja y multifactorial impulsada por una deficiencia en las lágrimas naturales, ya sea por una disminución en la producción de lágrimas o por una mayor evaporación de las mismas. Muchas de las opciones de tratamiento de la EOS comúnmente utilizadas tienen limitaciones, como un inicio lento del tratamiento, la insatisfacción del paciente y la mala adherencia. Entre los pacientes con ojo seco encuestados, solo el 13 % consideró que su ojo seco estaba bien controlado.
Esta aprobación está respaldada por dos ensayos clínicos de fase 3 que evaluaron a más de 930 pacientes (aleatorizados 1:1 a Tryptyr o vehículo) con antecedentes de EOS. En COMET-2 y COMET-3 (ensayos clinicos de





fase 3), hasta cuatro veces más pacientes que recibieron Tryptyr® experimentaron un aumento de al menos 10 mm en la producción natural de lágrimas el día 14, en comparación con el vehículo: 42,6 % frente al 8,2 % de los pacientes en COMET-2 y 53,2 % frente al 14,4 % en COMET-3 (ambos p < 0,0001). Se observaron resultados consistentes en todos los puntos temporales hasta el día 90. Tryptyr® demostró una producción natural de lágrimas estadísticamente significativa desde el día 1
Estudios en animales sugieren que el acoltremon, el principio activo de Tryptyr®, es un agonista de los termorreceptores de potencial transitorio de melastatina 8 (TRPM8). Se ha demostrado que la estimulación del termorreceptor TRPM8 activa la señalización del nervio trigémino, lo que provoca un aumento de la producción basal de lágrimas. Se desconoce el mecanismo de acción exacto de acoltremon en la EOS.
Tryptyr® está disponible en viales monodosis fáciles de usar: una gota por ojo, dos veces al día. Alcon prevé lanzar acoltremon en EE. UU. en el tercer trimestre de 2025 y prevé llevar acoltremon a otros mercados en el futuro.
Fuente: https://www.drugs.com/newdrugs/fda-approves-tryptyr-acoltremon-ophthal mic-solution-dry-eye-6537.html

La Universidad de Antioquia recibió el registro sanitario del Invima que la autoriza a fabricar cloroquina de manera industrial en la Planta de Producción de Medicamentos Esenciales. Este es el primero de varios medicamentos estratégicos que tendrán el sello UdeA y aportarán a la soberanía farmacéutica en Colombia. La cloroquina es clave en el tratamiento de la malaria, una enfermedad desatendida en el país que, según el Ministerio de Salud, registra un promedio entre 50.000 a 100.000 casos al año.
Tras la entrega del registro sanitario a la UdeA y la respectiva emisión de la orden de compra, se proyecta que en los próximos dos meses se realice la entrega a Minsalud del primer lote de cloroquina de 150 mg, compuesto por 240.000 tabletas, de un total de 1.300.000 unidades que la entidad adquiere anualmente para distribuir y así suplir la demanda nacional
Niclosamida, benznidazol y praziquantel son los otros tres medicamentos estratégicos incluidos en el convenio firmado con el Ministerio de Salud. Se espera que sus respectivos registros sanitarios estén listos antes de finalizar el año.
Cabe anotar que finalizando el 2024, la UdeA firmó otro convenio con los ministerios para producir, por primera vez en Colombia, un medicamento a bajo costo para el tratamiento del VIH, también se encuentran trabajando en el desarrollo del dolutegravir triconjugado con miras a obtener su registro Invima e iniciar su producción a inicios del 2026.
A raíz de los logros alcanzados en la producción nacional de medicamentos, y como un nuevo voto de confianza en la Universidad de Antioquia, el Ministerio de Salud y Protección Social, el Ministerio de Ciencia, Tecnología e Innovación y la Alma Máter firmaron dos nuevos convenios con los que se espera avanzar hacia la soberanía farmacéutica en Colombia.













Por un lado, se suscribió un convenio para realizar todo el proceso de desarrollo y fabricación de la primaquina en presentaciones de 5 y 15 mg, un medicamento que complementa la lucha contra la malaria. Mientras la cloroquina se utiliza para tratar la enfermedad, la primaquina es un medicamento que ayuda a prevenirla. El segundo convenio suscrito involucra a la Central de Mezclas de la UdeA, también adscrita a la Facultad de Ciencias Farmacéuticas y Alimentarias y ubicada en el

Hospital Alma Máter, en la que se desarrollará una línea de filtración esterilizante para fabricar, a nivel magistral, medicamentos vitales no disponibles y antídotos para casos de intoxicación. Se trata de un sistema diseñado para garantizar que las preparaciones farmacéuticas estén completamente libres de microorganismos, asegurando el cumplimiento de los estándares de calidad y esterilidad, sin comprometer la estabilidad del principio activo.



Fuente: https://www.udea.edu.co/wps/portal/udea/web/inicio/udea-noticias/udea-no ticia/!ut/p/z0/fYyxbgIxEER_hYbSskOOSyhPFJEiCgqEwA0a7FWyxPYePnPi83MHB aKhGc3svhlt9U7bhJ5_UFgSwpD3tj58Lpazt6YyK1NXtWnqdTX_mH29b7ZGf2v7G hgW-HQ-20ZbJ6nQtehdK7kgXDxhatA9p1-JdPejTpIUdoxuam7txF5G6nHuxDF5DuvMjk-kkKPoDwFxannCNUiD5LFXxxnFcmzQ6RURI2zwy9ARQRkhm7_7P4f2FT sBw!!/




Kenvue, fabricante de Tylenol, presenta una nueva línea de suplementos sin fármacos para la salud articular y la movilidad. Según la compañía, su línea Proactive Support, que incluye una mezcla de ingredientes naturales clínicamente estudiados, representa un avance notable en el sector de los suplementos. Kenvue afirma que la innovación responde a una creciente demanda de soluciones no farmacéuticas para los problemas articulares relacionados con la edad y el estilo de vida
Este lanzamiento expande la marca Tylenol al ámbito de los suplementos y ofrece a los consumidores un portafolio que les permite construir un conjunto más completo de herramientas para el bienestar.
La base de la nueva línea es TamaFlex, una mezcla patentada de cúrcuma y tamarindo. La compañía afirma que estudios clínicos demuestran que puede mejorar la comodidad, la flexibilidad y la función articular en tan solo cinco días, al favorecer la respuesta inflamatoria saludable del organismo.
Además, fue desarrollado con aportes de profesionales de la salud y está diseñado para consumidores que buscan una solución fácil de tomar una vez al día sin la necesidad de tomar múltiples píldoras grandes.
Con Proactive Support, Tylenol dice que está abordando una necesidad de salud clave, ya que las investigaciones muestran que el proceso de envejecimiento se acelera alrededor de los 44 años y nuevamente a los 60, etapas de la vida en las que la salud de las articulaciones se vuelve más vulnerable al desgaste y al estrés. Proactive Support viene en dos fórmulas pendientes de patente: Muscle & Joint y Muscle & Joint + Stress.
Muscle & Joint contiene extracto de pepino, que ofrece beneficios para el bienestar articular que, según la compañía, superan a los de la glucosamina y la condroitina.
Muscle & Joint + Stress añade extracto de esceletium para ayudar a controlar el estrés ocasional y promover una sensación de calma. Tylenol destaca que ambas opciones no contienen acetaminofén.
Fuente: https://www.nutritioninsight.com/news/kenvue-tylenol-natural-joint-support -supplements.html

En el marco del FIFARMA Annual Summit 2025, fueron presentados los resultados de la Encuesta de Competitividad
Biofarmacéutica e Inversión (BCI) 2025, un estudio realizado por FIFARMA en alianza con Pugatch Consilium. Este informe evalúa el grado de competitividad de los países para atraer inversiones en el sector biofarmacéutico, considerando cinco pilares
fundamentales: capacidades científicas, investigación clínica, eficiencia regulatoria, acceso al mercado y protección de la propiedad intelectual.
La encuesta evidenció un rezago preocupante para América Latina frente a economías innovadoras como Singapur o Israel, que obtienen puntuaciones entre el 75 % y 85 %.
Mientras el promedio regional latinoamericano alcanzó un 59 %, las diferencias dentro del bloque son significativas: Costa Rica (70 %), Chile (68 %) y México (65 %) lideran el ranking, mientras que países como Colombia (53 %) y Ecuador (47 %) ocupan los últimos lugares
Colombia registró un puntaje del 53 %, lo que representa una caída de tres puntos porcentuales frente a su resultado de 2017 (56 %). De los cinco pilares analizados, el país mostró su mejor desempeño relativo en investigación clínica (63 %), seguido por acceso al mercado (54 %), capacidades científicas (54 %), sistema regulatorio (50 %) y, en último
lugar, protección de la propiedad intelectual (44 %). Pese a contar con un mercado farmacéutico robusto que generó ventas por 4.950 millones de dólares en 2021, Colombia no logró consolidar ese potencial en una estrategia sostenida para atraer inversión e innovación biofarmacéutica.
Uno de los factores más críticos identificados en el estudio es el deterioro del ecosistema de protección de la propiedad intelectual, que cayó casi un 9 % respecto a 2017. La baja puntuación (44,25 %) en esta categoría se atribuye a decisiones de política pública como la emisión de licencias obligatorias para medicamentos en 2024.
Otro hallazgo clave del BCI 2025 es la limitada disponibilidad de medicamentos innovadores en la región. Según un estudio complementario de FIFARMA e IQVIA, solo el 44 % de los más de 400 medicamentos aprobados mundialmente entre 2014 y 2024 cuentan con autorización en algún país latinoamericano, y apenas el 33 % están disponibles en los sistemas públicos de salud.
El informe propone además una serie de reformas coordinadas y sostenidas para avanzar hacia un entorno más competitivo.
Fuente: https://consultorsalud.com/colombia-penulti-competitividadbiofarmaceutica/




Intervención magistral de nuestro
Gerente Técnico QF. Alejandro Restrepo


